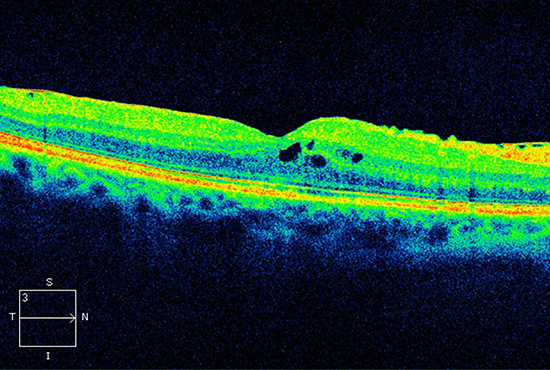

Lindenstraße 5 | 94072 Bad Füssing
Telefon: +49 (0) 8531 135095
E-Mail: info@optical-wellness.de
Startseite » Augenleiden » Makuladegeneration
Der Begriff Makuladegeneration umfasst verschiedene Erkrankungen der Netzhaut, die die Makula betreffen. In der Makula liegt der Punkt des schärfsten Sehens, der im Laufe der Erkrankung zunehmend an Funktionalität einbüßt. Eine Makuladegeneration kann zu einer hochgradigen Sehbehinderung und Blindheit führen. Man unterscheidet die trockene von der feuchten Krankheitsform.
Wir haben Ihnen hier die wichtigsten Informationen zum Entstehen, den Symptomen, der Diagnose und der von uns speziell entwickelten Therapiekombination zusammengestellt. Entscheidend für eine effektive Linderung Ihrer Beschwerden und die Therapie Ihres Leidens ist das persönliche Gespräch. Wir laden Sie dazu herzlich ins Zentrum für komplementäre Augenheilkunde in Bad Füssing ein.
Wenn Sie eine Beratung oder direkte Terminvereinbaren wünschen, rufen Sie uns direkt an:
oder fordern Sie über das unten stehende Formular Ihren schnellstmöglichen Rückruf an:


Reduzierung der hellen Drusen und Verbesserung des natürlichen Netzhautstoffwechsels


Reduzierung der Netzhautödeme, Stabilisierung der Blutgefäße
Ödem in der Netzhaut vor der Behandlung

Ödembildung nach der Behandlung deutlich reduziert
hier ermitteln wir die Antwort auf Ihre Fragen:
Krankheitstendenzen erkennen, lange bevor die üblichen Laborparameter abweichen.
Diese allgemeinen Störfaktoren werden vor Therapiebeginn behoben, damit wir ein optimales Ansprechverhalten auf die Therapie Ihrer Makuladegeneration erziehlen.
Wir lassen Sie nicht alleine, auch nach der aktiven Therapie erhalten Sie von uns weiterhin eine optimierte
Mediaktion auf homöopathischer Basis.
Die Makula (Makula lutea oder „gelber Fleck“) ist die Stelle des schärfsten Sehens in der Mitte der Netzhaut. Hier liegen in hoher Dichte als „Zapfen“ bezeichnete Fotorezeptoren vor. Sie vermitteln das scharfe Sehen – von Gesichtern, Gegenständen und Farben, von kontrastreichen Bildern und feinsten Details, etwa Buchstaben oder Ziffern einer Uhr. Außerhalb der Makula überwiegen Sinneszellen vom Typ der „Stäbchen“. Die „Stäbchen“ arbeiten in der Dämmerung, nehmen Hell-Dunkel-Kontraste, Umrisse und Bewegungen wahr und helfen bei der Orientierung im Dunkeln. Da diese von der Degeneration weniger betroffen sind, bleibt selbst bei ausgeprägtem Sehverlust ein Rest von peripherer Sehleistung erhalten. Betroffene können sich, obgleich gesetzlich blind, erstaunlich gut im Raum bewegen. Zum Beispiel bereitet Einkaufengehen in der Regel keine Schwierigkeiten, das Bezahlen an der Kasse oder das Erkennen von Gesichtern oder Preisschildern ist jedoch ein großes Problem.
Ablagerungen (Drusen) unter der Makula sind Kennzeichen der trockenen Form der Makuladegeneration. Bei der feuchten Form wachsen weniger stabile Blutgefäße unter der Makula.
Die Makuladegeneration geht von der Pigmentschicht der Netzhaut (retinales Pigmentepithel) aus. Dieses Gewebe ist in die fotochemischen Prozesse beim Sehvorgang eingebunden, also in die chemischen Reaktionen, die durch das Licht ausgelöst werden. Dabei fallen zahlreiche Stoffwechselprodukte an, die von der Pigmentschicht verarbeitet und entsorgt werden müssen. Offenbar bewältigt das Gewebe im höheren Alter seine Aufgaben nicht mehr richtig.
Wie sich zeigte, spielen hier Enzymreaktionen eine wichtige Rolle. Einer davon führt dazu, dass ein Funktionseiweiß fehlt, das für die Lichtrezeptoren bedeutsam ist. In der Folge kommt es in der Pigmentschicht der Netzhaut zur Ablagerung kleiner weißlich-gelber Partikel, den Drusen. Diese Drusen verhindern den Stoffwechsel der Lichtrezeptoren (Zapfen und Stäbchen) der Netzhaut. Weitere Enzyme, die bei Entzündungen und dem Transport von Proteinen und Lipiden eine Rolle spielen, sind ebenfalls von Bedeutung.
Bei Menschen im Alter über 60 Jahren findet der Augenarzt häufiger Drusen. Sie sammeln sich vor allem unter der Makula an. Mit der Zeit können sie zunehmen und die Ernährung der Netzhaut verschlechtern. Sie gelten als Auslöser der altersbedingten Makuladegeneration (AMD) und als Merkmal der trockenen Form. Einzelne Drusen allein verursachen meist noch keinen oder nur einen geringen Sehverlust. Wenn sie jedoch zusammenfließen oder sehr groß werden, ist das Risiko für eine feuchte AMD deutlich erhöht. In dem Maße, wie die Pigment- und Gefäßschicht im Makulabereich zugrunde geht, sterben Sehzellen langsam ab. Die Makula wird ausgedünnt, und die AMD schreitet fort und führt zu einer geografischen Atrophie, Kennzeichen einer fortgeschrittenen trockenen AMD.
Ein bei der Krankheit aktives Eiweiß namens VEGF fördert das Wachstum von Blutgefäßen unter der Makula aufgrund der Stoffwechselprobleme der Lichtrezeptoren (Fotorezeptoren). Dagegen wirkt die Behandlung mit speziellen Medikamenten (VEGF-Blockern). Die neuen Gefäße sind ein Versuch des Auges, die Situation hinsichtlich der Durchblutung der Netzhaut zu verbessern. Da die Gefäße jedoch weniger stabil sind, schaden sie nur. Es tritt leicht Blutflüssigkeit aus, wodurch die Makula anschwillt (Makulaödem). Dann ist das Sehen verzerrt. Zudem kann sich die Pigmentschicht der Netzhaut von der Unterlage abheben und dadurch die Sehzellen schädigen. Im Zuge dessen ist auch ein plötzlicher Sehverlust möglich. Dann tritt im zentralen Sehbereich ein Bildausfall als dunkler Fleck auf – je mehr Sinneszellen (Fotorezeptoren) geschädigt wurden, desto größer ist der Defekt.
Alles, was im Mittelpunkt unserer Aufmerksamkeit steht, was wir also fixieren – was Sie hier gerade lesen –, wird in der Makula abgebildet, der Stelle des schärfsten Sehens in unserer Netzhautmitte.
Das häufigste Erstsymptom bei trockener Makuladegeneration sind Lichtempfindlichkeit und unregelmäßig auftretende „Lichtblitze“. Im Erststadium klagen Betroffene häufig darüber, dass das, was sie direkt ansehen, seit einiger Zeit unscharf erscheint. Später erst ist eine verminderte zentrale Sehschärfe wahrnehmbar. Das Lesen ist erschwert, die Betroffenen benötigen mehr Licht im Alltag. Am häufigsten sind sie dadurch gestört, dass sie bekannte Menschen, die ihnen auf der Straße begegnen, nicht erkennen, was zu unangenehmen Situationen führen kann. Das macht den Patienten oft große Sorgen. Im mittleren und fortgeschrittenen Stadium zeigt der Augenhintergrund viele, auch größere Drusen. Die Pigmentschicht und die darunter liegende Gefäßschicht der Netzhaut sind stellenweise ausgedünnt. Schließlich nehmen manche AMD-Patienten einen dunklen oder nebligen Fleck wahr. Dieser weist darauf hin, dass das zentrale Sehvermögen ausgefallen ist.
Zwei Drittel der von fortgeschrittener Makuladegeneration Betroffenen haben die feuchte Form. Sie wird nicht in weitere Stadien untergeteilt, obwohl immer wieder auch hier von frühen Stadien gesprochen wird, in denen bestimmte Therapieverfahren noch sinnvoll eingesetzt werden können. Letztlich muss die feuchte Makuladegeneration aber immer als fortgeschritten eingestuft werden – einfach deshalb, weil sich der Schaden sehr schnell entwickelt.
Bei feuchter Makuladegeneration erscheinen gerade Linien wegen der Makulaschwellung (Ödem) verzerrt – das kann übrigens auch bei trockener AMD der Fall sein. Zusätzlich aber kann auch ein dunkler Fleck in der Mitte des Blickfelds als Zeichen des zentralen Sehverlusts auftreten. Bei der augenärztlichen Untersuchung zeigen sich im Makulabereich neu gebildete Gefäße, Blutungen, eine abgehobene (verdickte) oder eingerissene Pigment- oder Sinneszellschicht. Es können auch Narben entstanden sein. Schreitet die Makuladegeneration fort, werden Lesen, Schreiben, Handarbeiten und viele andere Alltagsaktivitäten bis hin zum Autofahren zum Problem. Ein aktives, selbstständiges Leben mit sozialen, kulturellen oder sportlichen Aktivitäten ist praktisch nicht mehr möglich.
So löst eine AMD bei einem Teil der Betroffenen auch Ängste, Unsicherheit, Pessimismus und schließlich sogar Depressionen aus. Zwar mündet die Makuladegeneration nicht in einer vollständigen Erblindung. Doch das restliche Sehvermögen ist bei vielen Menschen so gering, dass sie als blind gelten (funktionelle Blindheit) und Anspruch auf Blindengeld beziehungsweise Blindenhilfe haben (beide Begriffe bedeuten zwar dasselbe, werden aber bundesweit uneinheitlich verwendet).
Die Früherkennungsuntersuchung erfolgt im Zentrum für komplementäre Augenheilkunde schon in jungen Jahren bei jeder Augenglasbestimmung und hat nicht nur zum Ziel, Ihre Sehschärfe zu überprüfen und gegebenenfalls zu korrigieren. Eventuelle Augenbeschwerden oder Sehstörungen werden dabei ebenfalls richtig eingeordnet. Vor allem sollen bislang unentdeckte Augenerkrankungen – wie die altersbedingte Makuladegeneration (AMD) – erkannt und ihre Behandlung eingeleitet werden, um so Ihr Augenlicht bestmöglich zu erhalten oder zu verbessern.
Bei der Erstuntersuchung erfassen wir Ihre Krankengeschichte (Anamnese), soweit sie für die Augen wichtig ist. Wenn Ihnen Verzerrtsehen (Metamorphopsie) Sehschwierigkeiten bereitet, führen wir den Amsler-Gitterlinien-Test durch.
Mit der Zeiss Visucam 200 mit Makula-Pigmentdichtenmessung-Modul steht uns ein innovatives Bildanalyseverfahren zur Verfügung, mit dem sich der schützende Farbstoffgehalt der Netzhaut schnell und schonend bestimmen lässt. Damit haben Sie die Möglichkeit, Ihr individuelles Risiko zur Entwicklung einer schweren Netzhauterkrankung frühzeitig zu erkennen und mit entsprechenden Maßnahmen gegenzusteuern. Die Makula-Pigmentdichtenmessung dient auch dazu, Defizite in der Mikronährstoffversorgung der Netzhaut sowie den Erfolg einer Vitamin-Therapie mit Lutein/Zeaxanthin zu beurteilen.
Ihre vorderen und mittleren Augenabschnitte, also Augenlider, Bindehaut, Lederhaut, Hornhaut, Iris und Augenlinse werden mit der Spaltlampe untersucht. Das Gerät entspricht einem Tischmikroskop, das mit einer starken Lichtquelle ausgestattet ist. Das Licht wird zu einem feinen Strahl gebündelt. Die genannten Strukturen lassen sich so wie durch ein Mikroskop vergrößert betrachten.
Bereits bevor eine Seheinschränkung auftritt, können Veränderungen in der Netzhaut einschließlich Makula und Sehnervenkopf durch die Spiegelung des Augenhintergrunds (zum Beispiel mit der Zeiss Visucam) ganz ohne Pupillenerweiterung erkannt werden.
Auch die Indozyaningrün-Angiografie wird in unserem Haus nicht angeboten, sie soll aber der Vollständigkeit halber erwähnt werden. Diese Form der Gefäßdarstellung kommt seltener als die vorher beschriebene zum Tragen. Verwendet wird dabei ein spezieller Farbstoff (Indozyaningrün), der krankhafte Gefäßneubildungen noch besser sichtbar macht.
Mit dem OCT-Gerät lässt sich die Dicke der Netzhaut bestimmen. Bei trockener AMD kann sie dünner, bei feuchter AMD dicker als normal sein. Hierbei können wir im Zentrum für komplementäre Augenheilkunde die Netzhaut in einzelnen Schnittbildern betrachten und dokumentieren. Die OCT ist schmerzfrei, berührungslos und dauert nur wenige Sekunden. Die Pupillen müssen dank neuerster Zeiss-Technologie nicht durch Augentropfen erweitert werden. In der Regel sitzen Sie dazu vor dem Gerät und fixieren einen bestimmten Leuchtpunkt, während ein ungefährlicher Lichtstrahl die nötigen Messungen vornimmt. Da die Auflösung hoch ist, können unser Heilpraktiker und unsere Augenoptikermeister selbst kleinste Veränderungen wie etwa Drusen im Rahmen der AMD sehen.
Bei weiteren Auffälligkeiten führen wir ergänzende Untersuchungen durch, die zu den Standarduntersuchungen in unserer Augenoptik gehören, z. B.: die Gesichtsfeldmessung (Perimetrie), eine Fotografie der Papille, eine Optische Kohärenztomografie (OCT), bei der speziell der Sehnervenkopf durch ein unschädliches Laserlicht dreidimensional vermessen wird. Weil eine dickere oder dünnere Hornhaut die Messung des Augeninnendrucks verfälschen kann, geht dem meist auch eine Ermittlung der Hornhautdicke (Pachymetrie) voraus.
Bei der trockenen AMD geht uns vor allem darum, die normalen Funktionen des Retinalen Pigmentepithels wiederherzustellen und zu stabilisieren und eventuell bereits entstandene Drusen zu vermindern. Dies geschieht in einem speziell auf Sie zugeschnittenen Behandlungs- und Medikationsplan aufgrund der bei Ihrer Erstuntersuchung ermittelten, auslösenden Faktoren.
Die biomolekulare hi-med-Therapie nutzt natürliche regulatorisch und metabolisch wirkende organische Substanzen und Enzyme sowie eine Kombination aus Akupunktur, Oxyvenierung und verschiedenen physikalischen Behandlungen, um die aus dem Gleichgewicht geratenen Prozesse wieder zu normalisieren. Damit ist eine kausale Behandlung Ihrer Makuladegeneration möglich. Die erkrankten Zellstrukturen sollen durch diese biologische Vitalisierung regeneriert werden.
Beeinflussbare Risikofaktoren auszuschalten und gesund zu leben, rundet Ihren Therapieplan ab. Neben einem ausreichenden Maß an Bewegung und dem Verzicht auf Nikotin zählt dazu auch eine gesunde Ernährung vorrangig mit vitaminreicher Frischkost.
Spezielle Behandlungswege können, rechtzeitig angewandt, eine feuchte Makuladegeneration aufhalten oder verlangsamen. Eine Heilung ist leider noch nicht möglich. An erster Stelle steht in unserem Behandlungsspektrum die Stabilisierung der dünnen, neugebildeten Blutgefäßwände und die Hemmung der Gefäßneubildung.
Der Botenstoff VEGF (Abkürzung für engl. vascular endothelial growth factor, auf Deutsch: Gefäßendothel-Wachstumsfaktor) lässt Blutgefäße wachsen. Bei der feuchten altersbedingten Makuladegeneration (AMD) ist der Wachstumsfaktor dafür verantwortlich, dass neue Gefäße bis zur Netzhautmitte vordringen. Durch Einrisse in diesen neuen, weniger stabilen Gefäßen entstehen Blutungen, die die Makula schädigen. VEGF-Hemmstoffe können das Gefäßwachstum stoppen und eine Vernarbung der Gefäße herbeiführen. Das Ergebnis: Die Schwellungen trocknen aus. Die Medikamente werden durch den Arzt wiederholt direkt in den Glaskörperraum gespritzt. Zunächst erfolgen meist drei Injektionen in jeweils monatlichen Abständen. Anhand von monatlichen Kontrolluntersuchungen beurteilt der Augenarzt, ob die Maßnahme erfolgreich ist und die Therapie zeitweise ausgesetzt werden kann oder wiederaufgenommen werden sollte. Der Augenarzt wird entscheiden, welcher Arzneistoff sich zu Ihrer Behandlung am besten eignet.
Eine chirurgische Behandlung kommt zum Beispiel bei größeren Blutungen unter der Netzhaut in Betracht. Dabei wird eine Netzhaut-Glaskörperoperation (eine sogenannte pars-plana-Vitrektomie) durchgeführt. Zunächst entfernt der Operateur den Glaskörper. Dann schneidet er die Netzhaut in der Nähe der Blutung ein (Retinotomie) und saugt das Blut mit einem speziellen Instrument ab. Ist die Blutung nur wenige Tage alt, geht das problemlos. Ist bereits ein fester Blutpfropf entstanden, wird dieser mitsamt der neu gebildeten Gefäße durch den Einschnitt in der Netzhaut entfernt. Schließlich wird das Auge mit einem künstlichen Glaskörper (Silikonöl) gefüllt. Die Operation ist außerordentlich komplex und mit Risiken verbunden, vor allem mit einer möglichen Blutung während oder nach dem Eingriff. Blutverdünnende Medikamente müssen vorher unbedingt – und in Absprache mit dem behandelnden Arzt – abgesetzt werden. Die Aussichten auf eine Verbesserung der Sehschärfe sind sehr begrenzt.
Professionell angepasste Lesehilfen, die eine deutliche Vergrößerung des Bilds auf der Netzhaut ermöglichen, können Ihnen mit trockener oder feuchter AMD wieder zum Sehen im Nahbereich verhelfen und damit Lesen, Schreiben oder das Verrichten von Arbeiten ermöglichen. Dabei macht man sich die noch intakten Bereiche um Ihre Netzhautmitte herum und zum Rand hin – also das äußere Gesichtsfeld – zunutze. Je stärker die Vergrößerung ist, desto kleiner wird allerdings der Bildausschnitt. Daher benötigen Sie beim Umgang mit solchen Mitteln eine gewisse Übungsphase, Geduld und auch Geschick.
Infrage kommen
Lesegeräte sind relativ große Apparate und technisch (auch lesetechnisch!) gewöhnungsbedürftig. Ausgesprochenen „Leseratten“, die anders wirklich keine Lebensfreude mehr haben, ist damit jedoch viel geholfen.
Sie haben Fragen zur Makuladegeneration oder wünschen, persönlich beraten zu werden?
Wir nutzen Cookies auf unserer Website. Einige von ihnen sind essenziell, während andere uns helfen, diese Website und Ihre Erfahrung zu verbessern. Wenn Sie unter 16 Jahre alt sind und Ihre Zustimmung zu freiwilligen Diensten geben möchten, müssen Sie Ihre Erziehungsberechtigten um Erlaubnis bitten. Wir verwenden Cookies und andere Technologien auf unserer Website. Einige von ihnen sind essenziell, während andere uns helfen, diese Website und Ihre Erfahrung zu verbessern. Personenbezogene Daten können verarbeitet werden (z. B. IP-Adressen), z. B. für personalisierte Anzeigen und Inhalte oder Anzeigen- und Inhaltsmessung. Weitere Informationen über die Verwendung Ihrer Daten finden Sie in unserer Datenschutzerklärung. Sie können Ihre Auswahl jederzeit unter Einstellungen widerrufen oder anpassen.
Alle akzeptieren und speichern
Wenn Sie unter 16 Jahre alt sind und Ihre Zustimmung zu freiwilligen Diensten geben möchten, müssen Sie Ihre Erziehungsberechtigten um Erlaubnis bitten. Wir verwenden Cookies und andere Technologien auf unserer Website. Einige von ihnen sind essenziell, während andere uns helfen, diese Website und Ihre Erfahrung zu verbessern. Personenbezogene Daten können verarbeitet werden (z. B. IP-Adressen), z. B. für personalisierte Anzeigen und Inhalte oder Anzeigen- und Inhaltsmessung. Weitere Informationen über die Verwendung Ihrer Daten finden Sie in unserer Datenschutzerklärung. Hier finden Sie eine Übersicht über alle verwendeten Cookies. Sie können Ihre Einwilligung zu ganzen Kategorien geben oder sich weitere Informationen anzeigen lassen und so nur bestimmte Cookies auswählen.
